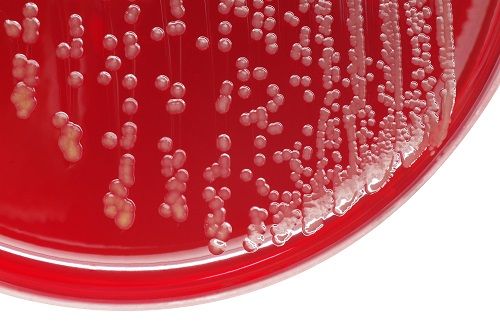

Skin & Soft Tissue Diseases
Latest News
Latest Videos

CME Content
More News

In a wounded mouse model concurrently infected with influenza A, investigators observed that the innate immune system prioritized responding to the lung infection, delaying wound healing.

Bruce Jones, PharmD, BCPS, discusses the growing burden of ABSSSI and why there have been an influx of MRSA cases.

There is a new treatment for this old disease, so why are we still worried?

Yoav Golan, MD, discusses trends in the incidence of acute bacterial skin and skin structure infections, standard protocols for treatment, and the challenges clinicians continue to face.

New geographical spread of the disease may warrant increased vigilance among labs and clinicians.

The PDUFA action date has been set for February 13, 2019.

The FDA advisory committee voted 17 to 1 in favor of omadacycline for treatment of ABSSSI and 14 to 4 for the treatment of CABP.

Following cases of vibriosis in New Jersey, Alabama, and Florida, health officials are telling individuals with open wounds to stay out of coastal or brackish waters.

Development of the drug has been deemed necessary because of the potential for the use of the virus in a bioterrorism attack and waning herd immunity against the virus among the general population.

Preliminary studies provide convincing evidence for the synergistic use of sulfonamide agents with azole antifungals.

Research presented at the 2018 ASM Microbe Meeting has reinforced the value of the just-approved next-generation aminoglycoside antibiotic, plazomicin, in treating multidrug-resistant Enterobacteriaceae.

Because of the global rise in antimicrobial resistance, meropenem-vaborbactam, the first carbapenem/β-lactamase combina­tion medication, is a welcome new antibac­terial.

Skin and soft tissue infections appear to be on the decline in the general population, but individuals with HIV have a higher risk.

Several recent studies provide valuable insight surrounding the appropriateness of transitioning from intravenous to oral therapy when treating bacteremic urinary tract infections.